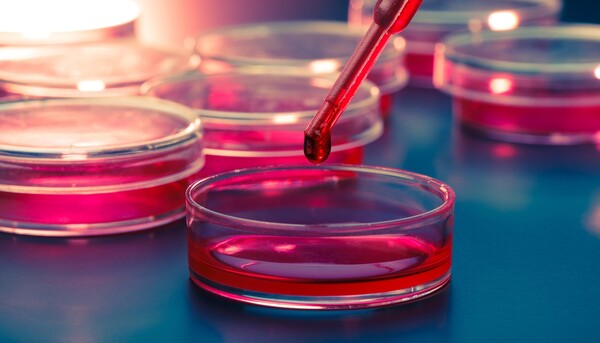

Επιστήμονες στη Βρετανία ανέπτυξαν ένα νέο τεστ αίματος, το οποίο μπορεί να εντοπίσει με ευκολότερο, φθηνότερο και ανώδυνο τρόπο τα παιδιά που έχουν αλλεργία στα φιστίκια.
Το νέο τεστ, που αναζητά βιοδείκτες τους οποίους απελευθερώνουν τα λευκά ανοσο-κύτταρα του αίματος, έχει ποσοστό επιτυχίας 98% στις διαγνώσεις, όπως έδειξε η δοκιμή του σε 174 παιδιά.
Οι ερευνητές, με επικεφαλής την δρα Αλεξάντρα Σάντος του Βασιλικού Κολλεγίου (King's) του Λονδίνου, που έκαναν τη σχετική δημοσίευση στο περιοδικό για θέματα αλλεργίας και κλινικής ανοσολογίας «Journal of Allergy and Clinical Immunology», σύμφωνα με τη Guardian, δήλωσαν ότι το νέο τεστ υπερτερεί σε σχέση με τα τωρινά ακριβά, χρονοβόρα και λιγότερο ακριβή τεστ.
Η αλλεργία στα φιστίκια -μία από τις συχνότερες παιδικές αλλεργίες σε τροφές- συνήθως επιβεβαιώνεται αφενός με ένα τεστ τρυπήματος του δέρματος (που μετρά την παρουσία των αντισωμάτων ανοσοσφαιρίνης IgE), αφετέρου με δοκιμαστική χορήγηση στα παιδιά ολοένα μεγαλύτερων ποσοτήτων φιστικιών.
Το νέο τεστ, με την ονομασία Mast Activation Test, κοστίζει μόνο το ένα πέμπτο σε σχέση με τα τωρινά. Θα πραγματοποιείται όταν το πρώτο τεστ (τρύπημα του δέρματος) δεν καταλήγει σε ασφαλή συμπεράσματα και προτού τα παιδιά υποβληθούν στο τεστ διατροφής.
Οι ερευνητές δήλωσαν ότι «με αυτό τον τρόπο θα μπορέσουμε να μειώσουμε κατά τα δύο τρίτα τον αριθμό των ακριβών και αγχωτικών τεστ διατροφής, αποφεύγοντας παράλληλα να υποβάλουμε τα παιδιά στο να βιώσουν την εμπειρία των αλλεργικών αντιδράσεων».
Η φαγούρα του δέρματος, οι πόνοι στο στομάχι και η αίσθηση ασφυξίας στο λαιμό και στους πνεύμονες είναι ανάμεσα στα συμπτώματα των αλλεργικών αντιδράσεων. Οι ερευνητές ήδη σχεδιάζουν να επεκτείνουν τη χρήση του τεστ και σε άλλες διατροφικές αλλεργίες πέρα από τα φιστίκια.
Πηγή: ΑΠΕ-ΜΠΕ